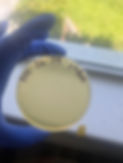
BHI-26-08-pHBM.jpg

PARASOL
THE FUTURE OF HEALTHCARE BEGINS NOW.
At Parasol Labs, we believe that our values are the cornerstone of our identity. Driven by a commitment to excellence, integrity, and innovation, we strive to transcend the ordinary in everything we do.
We're not just about making promises; we're about embodying them in every project, every breakthrough, and every interaction. Here, our actions speak louder than words, reflecting our unwavering dedication to impacting the world positively and paving the way for a brighter, healthier future.
MISSION STATEMENT
Parasol Laboratories Incorporated is dedicated to pioneering transformative solutions that solve global health needs, empower marginalized communities, and target underserved markets. We are driven by a deep-rooted ethos, prioritizing the well-being of our end users and the integrity of our data.
Every product we design, every decision we make, is anchored in creating a tangible, positive impact, with no compromise. Our responsibility extends beyond profit, as we reinvest in our community, ensuring equitable care and quality of life are forever at the forefront of our endeavors.
OPERATIONAL STATEMENT
Every day at Parasol Laboratories Incorporated, we operationalize our mission by engineering products with the end user's best interest in mind. Our pricing models allow us to produce more while giving back, ensuring that our innovations reach those who need them most, not just those who can afford them. We champion environmental responsibility, sustainability, and neutrality in all our processes.
​
Our team, our greatest asset, is nurtured in an environment that values their well-being, rewards their expertise, and encourages continuous growth. Together, we work towards building a lasting legacy of positive change and unparalleled impact, internally and externally.
